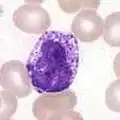

خلية دم بيضاء
الخلية البيضاء أو خلية الدم البيضاء أو الكرية البيضاء أو كرية الدم البيضاء هي إحدى خلايا الدم الرئيسية بالإضافة للخلية الحمراء والصفائح الدموية.[1][2][3] الوظيفة الرئيسية لهذه الخلايا هي الدفاع عن الجسم ضد الأمراض المعدية، وهي جزء من الجهاز المناعي. وهي خلايا الجهاز المناعي وظيفتها الدفاع عن الجسم ضد كل الأمراض المعدية والمواد المثيرة للجهاز المناعي هناك عدة أنواع مختلفة ومتنوعة من الكريات البيضاء، لكنها جميعا تتشكل من خلية جذعية متعددة القدرات في نخاع العظام المعروفة باسم خلية جذعية مكونة للدم.
| خلية الدم البيضاء | |
|---|---|
![]() صورة بواسطة المجهر الإلكتروني الماسح لدم الإنسان الطبيعي في مجراه. يمكن ملاحظة كريات الدم البيضاء غير منتظمة الشكل وخلايا الدم الحمراء والصفيحات الدموية قرصية الشكل صغيرة الحجم. | |
| تفاصيل | |
| يتكون من | خلية وحيدة ، وخلية لمفاوية ، وخلية متعادلة ، وخلية دم بيضاء قاعدية ، وخلية حمضة |
| نوع من | خلية دم |
| جزء من | دم |
| ترمينولوجيا هستولوجيكا | H2.00.04.1.02001 |
| FMA | 62852 |
| ن.ف.م.ط. | A11.118.637، وA15.145.229.637، وA15.382.490 |
| ن.ف.م.ط. | D007962 |
عدد الكريات البيضاء في الدم غالبا ما تكون مؤشرا على المرض. وهناك عادة بين 4000 - 11000 خلية دم بيضاء في مايكرولتر من الدم، أي ما يقارب 1% من الدم عند البالغين الأصحاء. أثناء تعرض الجسم لهجوم من الأنتيجينات (مولدات الضد) يرتفع هذا العدد قليلًا. في حالات مثل ابيضاض الدم (اللوكيميا) يكون عدد الكريات البيضاء أعلى من طبيعي، وفي نقص الكريات البيضاء يكون هذا العدد أقل من ذلك بكثير. الخصائص الفيزيائية للكريات البيضاء، مثل الحجم، والموصلية، والحبوبية، قد تتغير بسبب التفعيل أو بسبب وجود خلايا غير ناضجة أو خبيثة كما في ابيضاض الدم.
أصل التسمية
أطلق عليها اسم خلايا الدم البيضاء من حقيقة انه بعد إجراء التثفيل (الطرد المركزي) لعينة من الدم، فنلاحظ وجود الكريات البيضاء كطبقة رقيقة بيضاء من الخلايا المنواة بين رسابة خلايا الدم الحمراء وبلازما الدم. المصطلح العلمي كرة الدم البيضاء يعكس مباشرة هذا الوصف وهو مشتق من اليونانية leukos—الأبيض، وkytos – الخلية. بلازما الدم قد تكون أحيانا خضراء إذا كانت هناك كميات كبيرة من العدلات في العينة، ويرجع ذلك إلى الهيم – الموجود بالإنزيم Myeloperoxidase الذي تنتجه العدلات.
أنواع خلايا الدم البيضاء
هناك عدة أنواع مختلفة من خلايا الدم البيضاء. التقنية الأساسية لتصنيفها هي البحث عن وجود حبيبات، مما يسمح لتمايز الخلايا إلى فئات محببة وغير محببة.
- المحببة: تتكون في نخاع العظام الأحمر. وتتميز الكريات البيضاء بوجود حبيبات مختلفة في الهيولى عندما ينظر إليها تحت المجهر الضوئي. هذه الحبيبات هي إنزيمات مرتبطة بالغشاء وتقوم بهضم الجسيمات المبتلعة. وهناك ثلاثة أنواع من الكريات البيضاء المحببة: خلية متعادلة، خلية قاعدية، خلية حمضية والتي سميت حسب تلون كل منها.
- غير المحببة: تتكون في الأنسجة الليمفاوية كالطحال والكبد والغدد الليمفاوية. وتتميز هذه الكريات البيضاء بغياب الحبيبات في الهيولى. ورغم أن الاسم يعني عدم وجود حبيبات في هذه الخلايا لكنها تحتوي على حبيبات غير نوعية تشبه زرقة اللازورد، والتي هي الجسيمات الحالة. هذه الكريات البيضاء تشمل: اللمفاويات، وحيدات النوى، والبلاعم.
مدة حياتها
هي قصيرة جداً إذا قورنت بخلايا الدم فعمرها حوالي بضع ساعات في حالة الخلايا الليمفاوية ومن يوم إلى يومين في باقي الخلايا البيضاء، والخلايا البيضاء عادة ما تغادر الجهاز الدوري لتقوم بوظائفها بالأنسجة.
وظائفها
تقوم خلايا الدم البيضاء بالعديد من الوظائف الهامة وهي:
- الوظيفة الأساسية لها هي الدفاع ضد غزو الميكروبات.
- تفرز خلايا الأزينوفيل مادة الهستامين التي تؤثر على الأوعية الدموية فتسبب اتساعها كما تزيد في حالات الحساسية بالجسم.
- تفرز البيزوفيل مادة الهيبارين التي تمنع تجلط الدم.
- تفرز الخلايا الليمفاوية الأجسام المضادة التي إما أن تعادل سموم الميكروبات أو تعمل على ترسيب الميكروبات.
- وظيفة المونوسايت: فهي مثل النيتروفيل تقوم بالتهام البكتريا ولكنها لكبر حجمها فهي تستطيع أيضاً التهام البروتوزوا المختلفة كالأميبيا وغيرها وكذلك تساعد على التئام الأنسجة.
جدول شامل
| النوع | شكل ترسيمي | تحت المجهر | النسبة في دم البالغ | القطر (ميكرومتر) | الأهداف الأساسية | النواة | لون الحبيبات | العمر |
|---|---|---|---|---|---|---|---|---|
| خلية متعادلة Neutrophil |
![]() |
![]() |
40-75% | 10-12 | جراثيم وفطريات | عديدة التفصص | وردي شاحب | من 6 ساعات لعدة أيام حسب مكانها |
| خلية حمضية Eosinophil |
![]() |
![]() |
1-6% | 10-12 | في حالات الحساسية والطفيليات | ثنائية التفصص | وردية | 8-12 يوم |
| خلية قاعدية Basophil |
![]() |
![]() |
<1% | 9-10 | في حالات الحساسية | ثنائية أو ثلاثية التفصص | زرقاء كبيرة | 10-15 |
| لمفاوية Lymphocyte |
![]() |
![]() |
20-45% | 7-8 |
|
متلونة بشدة ومركزية | فقط الخلايا القاتلة | من أسابيع لسنوات |
| وحيدة Monocyte |
![]() |
2-6% | 14-17 | متعددة | على شكل كلية | لا حبيبات | من أشهر إلى سنوات | |
| بلعمية Macrophage |
![]() |
![]() |
N/A | 14-17 | متعددة | - | لا حبيبات | أيام |
الخلايا المتعادلة
مقالة مفصلة: خلية متعادلة
المتعادلة (بالإنجليزية: Neutrophil) أو المبلعمة مصطلح المبلعمة يرجع إلى أن الخلايا نشطة في البلعمة. تتعامل مع الدفاع ضد العدوى الجرثومية أو الفطرية وغيرها من العمليات الالتهابية الصغيرة. وعادة ما تكون أول المستجيبين إلى العدوى الميكروبية. حيث نشاطها ووفاتها بأعداد كبيرة يساهم بتشكيل القيح. لها نواة مفصصة ولذلك قد تبدو مثل خلية متعددة النوى، ومن هنا جاء اسم كرة الدم البيضاء متعددة النواة. الهيولى قد تبدو شفافة بسبب صغر الحبيبات المتلونة باللون الوردي الخفيف.
هذه الخلايا ليست قادرة على تجديد الجسيمات الحالة المستخدمة في هضم الميكروبات لذلك تموت بعد هضم عدد قليل من مسببات الأمراض. وهذا يشرح لماذا توجد في المقام الأول في القيح، وليس في الأنسجة.
الخلية القاعدية
الخلية القاعدية (بالإنجليزية: Basophil) هي المسؤولة بالدرجة الأولى للاستجابة للحساسية وللمستضد عن طريق إفراز مواد كيميائية كالهستامين.
الخلية الحمضية
مقالة مفصلة: خلية حمضية
الخلايا الحمضية (بالإنجليزية: Eosinophil) تتعامل أساسا مع العدوى الطفيلية. وزيادة عددها يمكن أن يكون مؤشر للإصابة الطفيلية. كما أنها الخلايا الالتهابية العالية الاستجابات الحساسية. أهم أسباب كثرة الأيوزينيات (تشمل الحساسية مثل الربو، وحمى القش ،الطفح الجلدي؛ وأيضا الإصابة الطفيلية) تحتوي عموما على النواة ثنائية الفصيصات. الهيولى فيها مليء بالحبيبات التي تحمل لون وردي - برتقالي عند التلوين بالأيوزين.
اللمفاوية
مقالة مفصلة: خلية لمفية
اللمفاويات (بالإنجليزية: Lymphocyte) هي أكثر الكريات البيضاء شيوعا في الجهاز اللمفاوي. اللمفاويات تتميز بأن نواتها غامقة غير مركزية، وتحتوي كمية قليلة نسبيا من الهيولى.
الدم يحتوي ثلاثة أنماط من اللمفاويات:
- الخلايا البائية B cells: تنتج الخلايا البائية الأضداد التي ترتبط بمسببات الأمراض لتدميرها. وإضافة لوظيفة الربط بعد هجوم لمسبب مرض فإن بعض الخلايا البائية يصبح لها القدرة على إنتاج الأجسام المضادة النوعية لمسبب المرض لتكون بمثابة الذاكرة لجهاز المناعة وتسمى خلايا الذاكرة
- الخلايا التائية T cells :
- خلايا CD4 والخلايا المساعدة لها دور في تنسيق الاستجابة المناعية وأهميتها في الدفاع ضد الجراثيم داخل الخلوية.
- الخلايا السمية و CD8 قادرة على قتل الخلايا المصابة بفيروس والخلايا الورمية.
- الخلايا القاتلة الطبيعية Natural killer cells: هي قادرة على قتل خلايا الجسم التي ترسل إشارات عند إصابتها من قبل فيروس أو عندما تصبح سرطانية.
البلعمية
الخلية البالعة أو الخلية البلعمية أو الخلية الأكولة (بالإنجليزية: Phagocyte) هي خلية حية تبتلع وتحطم الدخيل الغريب عن الجسم، مثل الكائنات الدقيقة وحطامها بعملية تسمى البلعمة.
الوحيدة
مقالة مفصلة: خلية وحيدة
الخلية وحيدة النواة (بالإنجليزية: Monocyte) نواتها لها شكل الكلية وتملك هيولى غزيرة. وظيفتها تشبه وظيفة "المكنسة الكهربائية" للخلايا العدلات، ولكن عمرها أطول بكثير لأن لها دور إضافي. حيث تقدم مسببات الأمراض إلى الخلايا التائية ليتم تشكيل الجسم المضاد أو حتى يتم تذكر مسبب الأمراض هذا مرة أخرى عند تعرض الجسم له. كما يمكن للخلايا وحيدة النواة مغادرة مجرى الدم إلى الأنسجة لتتحول إلى خلية بالعة لتزيل حطام الخلايا الميتة فضلا عن مهاجمة الأحياء الدقيقة الممرضة.
إن أيا من هذين الوظيفتين لا يمكن القيام بها من قبل العدلات بنفس كفاءة وحيدات النواة. وخلافًا للعدلات، فإن وحيدات النواة قادرة على تعويض جسيماتها الحالة بعد استعمالها ولهذا السبب يعتقد أن عمرها أطول من عمر العدلات.
أدوية تسبب نقص الكريات البيضاء
بعض الأدوية يمكن أن يكون لها تأثير على عدد ووظيفة خلايا الدم البيضاء. نقص الكريات البيضاء هو انخفاض في عدد خلايا الدم البيضاء قد يؤثر على مجمل تعداد الخلايا البيضاء أو نوع مجدد منها. فعلى سبيل المثال، إذا كان عدد العدلات منخفض، تكون الحالة قلة العدلات وبالمثل يكون تدني مستويات الخلايا اللمفية حالة قلة اللمفاويات.
الأدوية التي يمكن أن تسبب نقص الكريات البيضاء تشمل Clozapine وهو من الأدوية المضادة للذهان من آثاره غير المرغوبة غياب الكامل لجميع المحببات (العدلة، الأسسة، الحمضة). أدوية أخرى تشمل مثبطات المناعة مثل Sirolimus ،Mycophenolate Mofetil ،Tacrolimus، وCyclosporine. وأيضا الإنترفيرونات المستخدمة لعلاج التصلب المتعدد، مثل Rebif ،Avonex، وBetaseron يمكن أن تسبب نقص الكريات البيضاء.
المراجع
- "معلومات عن خلية الدم البيضاء على موقع thes.bncf.firenze.sbn.it". thes.bncf.firenze.sbn.it. مؤرشف من الأصل في 18 ديسمبر 2019. الوسيط
|CitationClass=تم تجاهله (مساعدة) - "معلومات عن خلية الدم البيضاء على موقع jstor.org". jstor.org. مؤرشف من الأصل في 13 مارس 2020. الوسيط
|CitationClass=تم تجاهله (مساعدة) - "معلومات عن خلية الدم البيضاء على موقع psh.techlib.cz". psh.techlib.cz. مؤرشف من الأصل في 18 ديسمبر 2019. الوسيط
|CitationClass=تم تجاهله (مساعدة)
- بوابة تشريح
- بوابة طب
- بوابة علم الأحياء الخلوي والجزيئي
- بوابة علم الأحياء